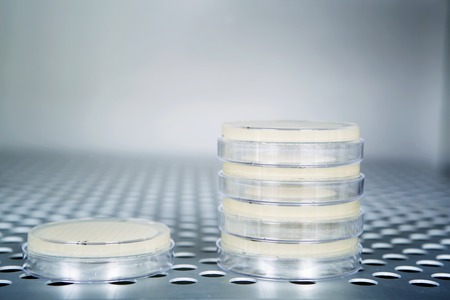
Petri dishes with a white liquids autoclave for sterilising surgical and other instruments inside.の写真素材

写真素材 - Petri dishes with a white liquids autoclave for sterilising surgical and other instruments inside.
作品情報
Petri dishes with a white liquids autoclave for sterilising surgical and other instruments inside.
- ID:50100403
- 作品種別:写真
- 作者名:Jekaterina Timofejeva
キーワード
- apparatus
- autoclave
- background
- chamber
- chemical
- chemistry
- clean
- clinical
- color
- dental
- dish
- door
- equipment
- experiment
- glass
- glassware
- green
- health
- heat
- instrument
- isolated
- lab
- laboratory
- liquid
- measurement
- medical
- medicine
- modern
- new
- open
- petri
- reagents
- reflection
- research
- science
- steam
- sterile
- sterilisation
- steriliser
- sterilization
- sterilizer
- technology
- temperature
- test
- tube
- veterinary
- water
- white
- yellow
- pressure
類似作品
Cosmetic swatch...
Background with...
Alternative nat...
Development Of ...
Petri dish with...
culture petri d...
Glass blurry ab...
A skin serum or...
Group of Petri ...
Petri dishes wi...
Abstract cosmet...
Abstract cosmet...
Cosmetic swatch...
Petri dish with...
Antiaging cosme...
Pouring liquid ...
Concept of scie...
Scientific rese...
glass Petri dis...
top view petri ...
Pipette with dr...
Glass petri dis...
Viruses and bac...
Laboratory glas...
color liquid in...
Pipette with Sa...
Different cosme...
Abstract cosmet...
Growth of diffe...
Microbiology La...
Biochemical Gla...
Top view of lab...
Glass lab dishe...
natural skincar...
Cosmetic swatch...
Pink, blue and ...
laboratory petr...
Different cosme...
tow glass labor...
Petri dish with...
Empty round pet...
Collagen white ...
Viruses and bac...
white mold grow...
Cosmetics on pe...
Group of scient...
Different cosme...
natural cosmeti...
petri dish with...